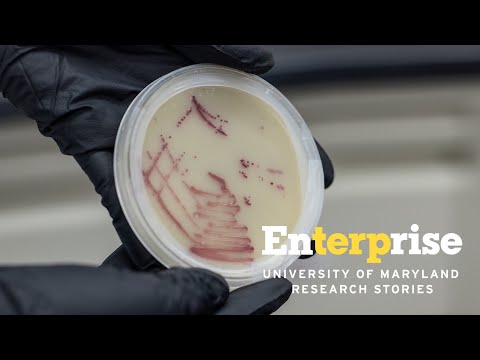
Keeping Maryland’s Water Safe | Enterprise Research Stories

Grand Challenges Grants
Videos
Plastic is a part of our daily lives, but it’s also posing a rising health risk worldwide 🌎
To limit plastic waste, UMD researchers are developing new, natural material composites to replace traditional plastic. Their work aims to replace current single-use plastics and limit microplastic ingestion for all.
Plastic is a part of our daily lives, but it’s also posing a rising health risk worldwide 🌎
To limit plastic waste, UMD researchers are developing new, natural material composites to replace traditional plastic. Their work aims to replace current single-use plastics and limit microplastic ingestion for all.
The Global FEWture Alliance is committed to alleviating food, energy and water insecurity while protecting global public health across communities worldwide. With 15 projects across the globe and over 275 students involved, these Terps have positively impacted over 7,000 people thanks to UMD’s Grant Challenges Grants.
Thanks to UMD's Grand Challenges Grants, the Maryland Initiative for Literacy and Equity (MILE) has partnered with all 24 Maryland public school districts to help kids become better readers. With the aid of programs like MILE, Maryland elementary school reading scores are on the rise!
Water is one of the keys to life, but exposure to contaminated water can be highly dangerous.
Aiming to combat this issue, UMD’s Water Emergency Team (WET) rapidly assists local residents impacted by sewer overflows or basement backups. Engaging a variety of communities across the state, utilizing evolving research technologies and analyzing infrastructure all contribute to WET’s mission.
The University of Maryland Center of Excellence in Microbiome Sciences joins faculty and students from across campus who are focused on providing actionable solutions that can improve human health, agricultural prosperity, and environmental sustainability from local to global scales.
The University of Maryland is helping to keep the residents and businesses in Maryland safe from severe weather with the Maryland Mesonet and Maryland Hydronet.
The Maryland Mesonet is a network of 70-75 (upon completion) rapid-sampling weather monitoring stations across the state. The Maryland HydroNet is a network of low-cost, continuous, near-real-time sea-level monitoring sensors installed on shorelines along the Chesapeake Bay.
Shirley Micallef, a professor of plant science and landscape architecture at the University of Maryland, is leading efforts to better understand the effects of microbial dynamics in an agricultural environment.
Her team conducted field trials on Maryland’s Eastern Shore and in Georgia, examining recommended safety protocols to prevent contamination from E. coli O157:H7 on leafy vegetables.
From harvesting rainwater and battling food insecurity to supporting education in underserved areas, our University of Maryland Grand Challenges Projects are Doing Good in our local community. President Pines visited these three projects to see their impact first-hand.
Asian American youth are often labeled as “model minorities,” yet beneath this stereotype lies a reality marked by discrimination and its intertwined impact on mental health. Suicide stands as the leading cause of death among Asian American youth ages 15-24. Associate Professor of School Psychology Cixin Wang discusses the importance of culturally tailored mental health interventions and the critical role parents play in fostering conversations about race and racism.
More than one billion people worldwide are food insecure while two billion lack access to safe drinking water. Thanks to funds from UMD’s Grand Challenges Grant Program, the Global FEWture Alliance is developing technology-based solutions, community-driven capacity building, and experiential education focused on these natural resources.
Thanks to the University of Maryland’s Grand Challenges Grant Program, MILE is taking on one of humanity’s grand challenges by working with parents and community members to help children develop into strong readers. A powerful partnership between UMD and Morgan State University, this initiative is key to ensuring a brighter future for all Maryland children.
Across the globe, shifting weather patterns impact farming, water and many aspects of daily life. Awarded one of three UMD Grand Challenges Institutional Grants, Addressing Climate Challenges for a Sustainable Earth aims to develop better tools to forecast severe weather and inform at-risk communities.
The Center of Excellence in Microbiome Sciences joins faculty, postdoctoral scholars and graduate students from across the University of Maryland in pursuit of a deeper understanding of complex microbial communities, and how those microbiomes interact with each other and with our ecosystem.
Maryland is proud to announce the winners of our Grand Challenges Grants, a $30 million investment in research addressing complex issues faced by our state, nation and world. Fifty winning projects across every school and college at UMD will receive funding to serve humanity and impact the public good.